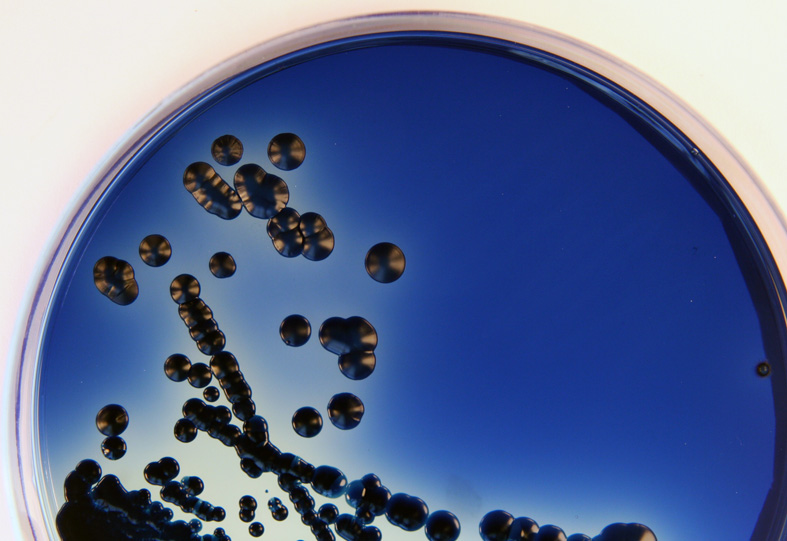

Aktuelle Projekte
Kontakt
Direktor
Sekretariat im Klinikum Oldenburg
Anschrift
Aktuelle Projekte
Proteus
 Bakterien, welche der Gattung Proteus angehören, sind ein besonderer Forschungsschwerpunkt. Proteus mirabilis ist ein Pathogen, welcher häufig Blasenentzündungen und Blutstrominfektionen verursacht. Auffällig an P. mirabilis ist die Fähigkeit, sich durch sogenanntes Swarming (Schwärmen) fortzubewegen und so neuen Lebensraum zu kolonisieren. Zudem werden P. mirabilis-Isolate, selbst wenn sie ein Resistenzgen gegen Carbapeneme tragen, mit derzeitigen Routine-Tests häufig fälschlicherweise als zu sensibel gegenüber Antibiotika eingestuft, was zu Fehltherapieren führen kann.
Bakterien, welche der Gattung Proteus angehören, sind ein besonderer Forschungsschwerpunkt. Proteus mirabilis ist ein Pathogen, welcher häufig Blasenentzündungen und Blutstrominfektionen verursacht. Auffällig an P. mirabilis ist die Fähigkeit, sich durch sogenanntes Swarming (Schwärmen) fortzubewegen und so neuen Lebensraum zu kolonisieren. Zudem werden P. mirabilis-Isolate, selbst wenn sie ein Resistenzgen gegen Carbapeneme tragen, mit derzeitigen Routine-Tests häufig fälschlicherweise als zu sensibel gegenüber Antibiotika eingestuft, was zu Fehltherapieren führen kann.
In der AG Medizinische Mikrobiologie beschäftigen wir uns ferner mit dem Vorkommen von Proteus Spezies in der Umwelt, in der Klinik und in Tieren. Hierbei ist insbesondere die Prävalenz von Antibiotika-Resistenzen relevant. Durch das Anlegen einer diversen Proteus-Stammsammlung soll die Diagnostik verschiedener Proteus Spezies in der klinischen Routine verbessert werden, sowie die Pathogenität erforscht werden.
Publikationen zu dem Thema:
Hamprecht, Axel et al. “Proteus mirabilis - analysis of a concealed source of carbapenemases and development of a diagnostic algorithm for detection.” Clinical microbiology and infection : the official publication of the European Society of Clinical Microbiology and Infectious Diseases vol. 29,9 (2023): 1198.e1-1198.e6. doi:10.1016/j.cmi.2023.05.032
Sattler, Janko et al. “OXA-48-like carbapenemases in Proteus mirabilis - novel genetic environments and a challenge for detection.” Emerging microbes & infections vol. 13,1 (2024): 2353310. doi:10.1080/22221751.2024.2353310
Diagnostik
 Um eine Infektion möglichst erfolgreich zu behandeln, ist eine schnelle und akkurate Diagnostik des Erregers essentiell. Insbesondere das Resistenzprofil eines Erregers ist ausschlaggebend für die richtige Behandlung einer erkrankten Person.
Um eine Infektion möglichst erfolgreich zu behandeln, ist eine schnelle und akkurate Diagnostik des Erregers essentiell. Insbesondere das Resistenzprofil eines Erregers ist ausschlaggebend für die richtige Behandlung einer erkrankten Person.
Die stete Weiterentwicklung von Pathogenen macht es wichtig, vorhandene und standardisierte Testverfahren regelmäßig zu prüfen und bei Bedarf zu verbessern und Arbeitsabläufe zu optimieren.
Publikationen zu dem Thema:
Hamprecht, Axel et al. “Proteus mirabilis - analysis of a concealed source of carbapenemases and development of a diagnostic algorithm for detection.” Clinical microbiology and infection : the official publication of the European Society of Clinical Microbiology and Infectious Diseases vol. 29,9 (2023): 1198.e1-1198.e6. doi:10.1016/j.cmi.2023.05.032
Sattler, Janko et al. “OXA-48-like carbapenemases in Proteus mirabilis - novel genetic environments and a challenge for detection.” Emerging microbes & infections vol. 13,1 (2024): 2353310. doi:10.1080/22221751.2024.2353310
Schaffarczyk, Lukas et al. “Detection of rare carbapenemases in Enterobacterales-comparison of two colorimetric and three CIM-based carbapenemase assays.” Microbiology spectrum vol. 12,2 (2024): e0301523. doi:10.1128/spectrum.03015-23
Thelen, Philipp et al. “A side-by-side comparison of the new VITEK MS PRIME and the MALDI Biotyper sirius in the clinical microbiology laboratory.” European journal of clinical microbiology & infectious diseases : official publication of the European Society of Clinical Microbiology vol. 42,11 (2023): 1355-1363. doi:10.1007/s10096-023-04666-x
One Health
Der Grundgedanke des One Health-Ansatz ist es, die Gesundheit von Menschen und Tieren nicht als alleinstehende Objekte zu betrachten, sondern als ein Zusammenspiel zwischen Mensch, Tier und Umwelt. Vor diesem Hintergrund beschäftigt sich die AG Medizinische Mikrobiologie mit dem Vorkommen sowie der Verbreitung von den Menschen befallenden Pathogenen in der Umwelt. Eine aktuelle Studie zeigt, dass in Gewässern in Niedersachsen (getestet wurden Seen, Flüsse und Kanäle), multiresistente Erreger vorhanden sind. Dies legt nahe, dass sich Pathogene und Resistenzgene auch über Wasser verbreiten können.
Publikationen zu dem Thema:
Cimen, Cansu et al. “Surface water in Lower Saxony: A reservoir for multidrug-resistant Enterobacterales.” One health (Amsterdam, Netherlands) vol. 17 100606. 27 Jul. 2023, doi:10.1016/j.onehlt.2023.100606
Verbreitung von Erregern und Resistenzgenen
Unter Verwendung von Next-Generation-Sequencing rekonstruiert die AG Medizinische Mikrobiologie Ausbrüche von Infektionen in hochsensiblen Bereichen, wie z.B. Intensivstationen. Dadurch können Übertragungswege wie die Übertragung über gemeinsam genutzt Gerätschaften aufgedeckt und in Zukunft verhindert werden.
Auch die Dissemination von Resistenzgenen zwischen Bakterien ist von starkem Interesse.
Publikationen zu dem Thema:
Cimen, Cansu et al. “Uncovering the spread of drug-resistant bacteria through next-generation sequencing based surveillance: transmission of extended-spectrum β-lactamase-producing Enterobacterales by a contaminated duodenoscope.” Antimicrobial resistance and infection control vol. 13,1 31. 8 Mar. 2024, doi:10.1186/s13756-024-01386-5
Tönnies, Hauke et al. “Investigating environmental transmission to resolve a Bacillus cereus group outbreak in a neonatal intensive care unit using core genome multilocus sequence typing.” Antimicrobial resistance and infection control vol. 13,1 1. 7 Jan. 2024, doi:10.1186/s13756-023-01359-0